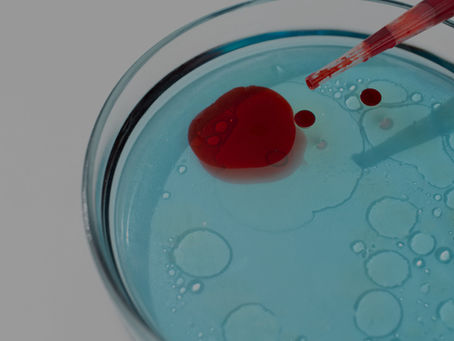
Sex-specific association of the hemoglobin, albumin, lymphocyte, and platelet score with urinary incontinence: A cross-sectional study

top of page
Search


Feasibility of Holmium Laser Enucleation of the Prostate After Prior Prostate Intervention for Benign Prostatic Hyperplasia
Abstract Objective: To evaluate the safety and outcomes of holmium laser enucleation of the prostate (HoLEP) in patients with a history of prior surgical prostate intervention, and to compare these results with the patients without previous prostate intervention. Methods: A retrospective review of a prospectively maintained database at a tertiary-level center in Texas. From August 2015 to February 2025, 1876 patients underwent HoLEP, 143 had previous prostate surgery. These w
urologyxy
1 day ago


Study on Symptom Management Theory-Based Nursing Treatment Model for Patients Undergoing Radical Prostatectomy: A Single-Center, Retrospective Experience
Abstract Background and Aims: Radical prostatectomy is the key for localised prostate cancer, but postoperative urinary incontinence and chronic pain impair outcomes. Enhancing perioperative care improves prognosis. This single-centre retrospective study evaluated a symptom management theory-based nursing model for radical prostatectomy patients. Methods: A total of 165 patients were divided into the control (routine care, n = 75) and observation (symptom management nursing,
urologyxy
Mar 9


A Positive Association Between Frailty and Overactive Bladder in United States Adults
ABSTRACT Background Frailty has been associated with numerous chronic diseases. However, the relationship between frailty and overactive bladder (OAB) has not been thoroughly examined. This study aims to explore the association between frailty and OAB in a large-scale population. Methods Data from 11 888 participants aged 20 years or older, who were part of the National Health and Nutrition Examination Survey (NHANES) from 2007 to 2018, were analyzed. The frailty index was ca
urologyxy
Mar 9


Urinary incontinence and its impact on the quality of life of adults 50 years or older: A study from a tertiary care teaching hospital in Al-Khobar, Eastern Province, Saudi Arabia
Abstract BACKGROUND: Urinary incontinence (UI) is a prevalent yet underreported condition that adversely affects the quality of life of older adults. This study aimed to assess the frequency and risk factors of UI and its impact on the quality of life of adults aged 50 years and older attending outpatient clinics of a tertiary care teaching hospital in the Eastern Province, Saudi Arabia. MATERIALS AND METHODS: This cross-sectional study was conducted from December 15, 2024,
urologyxy
Mar 9


The Prevalence and Characteristics of Difficult Patient Encounters: A Systematic Review and Meta-analysis
Abstract Background: Patients are sometimes experienced as difficult by their providers. Purpose: To estimate the prevalence of difficult patient encounters among adults being seen in nonpsychiatric settings. Secondary goals were to assess patient and provider characteristics associated with difficulty as well as patient outcomes. Data Sources: MEDLINE, Web of Science, SciELO, ProQuest, Theses, Scopus, PsychInfo, Cochrane Central Register of Controlled Trials, Global Index Me
urologyxy
Mar 7


Clinical and Liquid Biomarkers of 20-Year Prostate Cancer Risk in Men Aged 45 to 70 Years
Abstract Importance Prostate cancer incidence is projected to double by 2040, yet optimal risk stratification approaches for screening remain unclear despite recent international endorsements of organized programs that call for risk-adapted algorithms using readily available biomarkers. Objective To identify biomarkers for risk-adapted prostate cancer screening in men without prostate cancer. Design, Setting, and Participants This cohort study used data from the Study o
urologyxy
Mar 7


Prevalence and Determinants of Anorectal Disorders in Adult Patients with Urinary Incontinence: A Retrospective Cohort Study
Abstract Background/Objectives: Pelvic floor dysfunction (PFD) encompasses urinary incontinence (UI), anorectal disorders (ARDs), and other related conditions that frequently coexist. Evidence on the prevalence and determinants of ARD among patients with UI, particularly in Middle Eastern populations, remains limited. This study aimed to assess the prevalence of ARD in UI patients and identify key clinical and demographic factors associated with anorectal disorders. Methods:
urologyxy
Mar 7


Association between systemic immune-inflammation index and urinary incontinence: Evidence from the National Health and Nutrition Examination Survey
Abstract Objective This study examined the association between the systemic immune-inflammation index and urinary incontinence subtypes using data from National Health and Nutrition Examination Survey 2007–2016. Methods This cross-sectional study included 21,569 adults. Systemic immune-inflammation index was calculated and log-transformed. Survey-weighted logistic regression analyses, smoothed curve fitting, exploratory threshold analyses, and subgroup analyses stratified by
urologyxy
Mar 7


Intravesical Botulinum Toxin Type A for an Overactive Bladder: A Single-Center Audit
Abstract Background Intravesical administration of botulinum toxin type A (BoNT-A) is an established third-line intervention for patients with refractory overactive bladder (OAB). With BoNT-A therapy now widely adopted, ongoing audits remain important to capture real-world outcomes across different patient groups. This retrospective audit assessed the clinical outcomes of BoNT-A therapy in a heterogeneous patient population treated at a university-affiliated teaching hospital
urologyxy
Feb 27


Urinary incontinence in pulmonary rehabilitation: A common but insufficiently addressed comorbidity
To the editor, We read with great interest the recent multicenter prospective cohort study by Gravier et al. investigating the prevalence of urinary incontinence (UI) among individuals attending pulmonary rehabilitation (PR) and the effects of PR on urinary symptoms. The authors are to be commended for addressing an often overlooked but clinically relevant comorbidity in chronic respiratory disease (CRD) populations. The reported prevalence of UI (38%) in individuals attendin
urologyxy
Feb 27


Acanthus Condom Catheter: A Reusable and Adjustable Silicone Male External Catheter With Pressure-Sensitive Silicone Adhesive for Urinary Drainage
Abstract Condom catheters are also called external urinary collection devices to collect urine and monitor urine output in hospitalized and other patients with urinary incontinence. They play an important role in reducing catheter-associated urinary tract infections by using invasive indwelling catheters that are placed inside the bladder. Currently, male external catheters come with or without adhesives. Major problems with current condom catheters are finding the right size
urologyxy
Feb 23


S2k guideline on assistive device consultation for urinary incontinence from the German Society for Urology (DGU) – red flags, qualifications of consultants, costs
Abstract Background Counseling regarding a planned provision of medical aids is currently neither reimbursed nor regulated in Germany. It is offered by a range of providers with employees with varying levels of qualification and may be provided in a personal conversation, by phone, or remotely. In many cases, counseling is omitted entirely between the prescription and trial use or delivery of the product. The quality of medical aids counseling, which plays a key role in tempo
urologyxy
Feb 23


Impact of colour vision deficiency on bladder and colorectal cancer survival
Abstract Patients with colour vision deficiency (CVD) may not see blood in urine or stool, often the first sign of bladder or colorectal cancer, respectively. Here we sought to identify whether patients with bladder or colorectal cancer and CVD have worse outcomes when compared to matched patients without CVD, using an electronic health records research network (TriNetX). A total of 135 patients with CVD and bladder cancer showed shorter overall survival ( χ 2 = 4.85, P = 0
urologyxy
Feb 17

Sex-specific association of the hemoglobin, albumin, lymphocyte, and platelet score with urinary incontinence: A cross-sectional study
Abstract Urinary incontinence (UI) significantly impairs patients' normal social activities and physical exercise, posing a major public health and socioeconomic challenge. The association between the hemoglobin, albumin, lymphocyte, and platelet (HALP) score and UI has not been extensively investigated, with few studies examining potential gender differences in this relationship. This research aimed to evaluate gender-specific associations between the hemoglobin, albumin, ly
urologyxy
Feb 17


Guideline of guidelines: management of small testicular masses
Abstract Objective: To compare and summarise the most up to date international guidelines and major recommendations for the management of small testicular masses (STMs). Methods: A systematic search was conducted in PubMed, EMBASE, Scopus, Google Scholar, and the Cochrane Library up to 1 November 2024. The latest editions of five international guidelines were included in the review: the European Association of Urology 2025; the National Comprehensive Cancer Network 2024; the
urologyxy
Feb 12


Understanding self-inflicted penile strangulation: a case series analysis of clinical management and psychological considerations
Abstract Background: Injuries to the penis resulting from self-inflicted strangulation with various objects are uncommon, yet these injuries are more frequently observed in young adults. Medical literature has identified items such as hair, thread, rubber bands, metallic rings, and vacuum erection devices as tools used for this purpose. These constrictive items impede venous return from the penis, potentially leading to severe complications such as ischemia or necrosis. This
urologyxy
Feb 12


Association between sodium or salt intake and lower urinary tract symptoms: a systematic review
Abstract Background: High sodium intake is associated with cardiovascular and kidney disease, as well as the development of lower urinary tract symptoms (LUTS). The amount of salt intake can influence the development of symptoms, but reduction may benefit patients by lowering the presentation of LUTS. However, there is a lack of systematization of evidence between salt intake and LUTS. Objectives: Determine the relationship between a high salt intake and LUTS, and the impact
urologyxy
Feb 12


Severe chronic UTI sustained by clinically undetected intracellular Escherichia coli in a pediatric patient
Abstract Background: The presence of intracellular bacterial communities (IBCs) in the urothelium has been well documented in adults with chronic urinary tract infections (UTIs), but its long-term persistence going undetected in a severely symptomatic adolescent has not been reported. Case summary: We present the case of a 14-year-old girl suffering from debilitating chronic UTI symptoms and associated urinary incontinence for many years. Multiple antibiotic courses provided
urologyxy
Feb 9


Rapid direct disk diffusion testing for antibiotic resistance in urinary tract infections: a bacterial concentration-adjusted approach
ABSTRACT Urinary tract infections are among the most prevalent bacterial infections worldwide, typically diagnosed using clinical symptoms, dipstick tests, and laboratory methods requiring standardized bacterial suspensions for antibiotic susceptibility testing (AST). This study evaluated two rapid disk diffusion methods for urine samples that incorporate bacterial concentration into the analysis, eliminating the need for standardized suspensions. The threshold-adapted approa
urologyxy
Feb 3


Intermittent Catheters With Integrated Features Designed to Reduce the Risk of Urinary Tract InfectionFindings From the Continence Care Registry, a Multinational, Observational, Longitudinal Study
Abstract PURPOSE: The purpose of this analysis was to compare urinary tract infection (UTI) rates, health-related quality of life (QoL) and intermittent catheter (IC) experience, and satisfaction among participants who used hydrophilic ICs with a ring cap, protective introducer tip, and sleeve (Group A) to those who used ICs without this combination of features (Group B). DESIGN: Analysis of data from a prospective, observational, longitudinal continence care registry. SUBJ
urologyxy
Feb 3
bottom of page